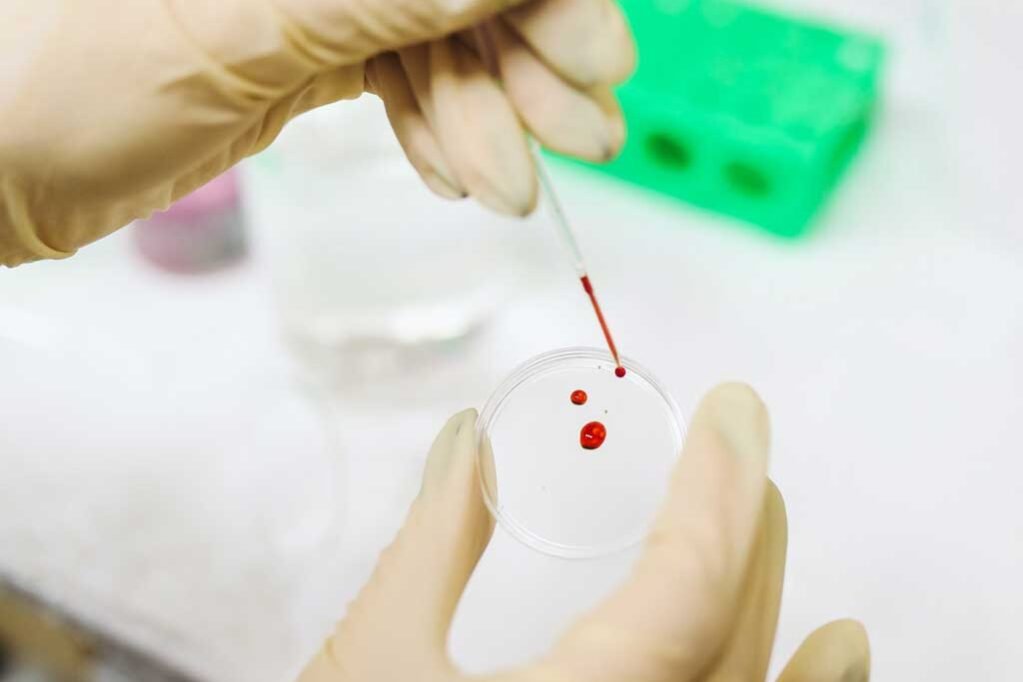
le-infiltrazioni-con-i-fattori-di-crescita le-infiltrazioni-con-i-fattori-di-crescita

Le infiltrazioni con i Fattori di Crescita. Alcune lesioni a livello muscolare oppure alcune infiammazioni dei tendini si possono molto spesso trattare, con gli ormai molto conosciuti fattori di crescita.
Che cosa sono? Cerchiamo di spiegare bene perché se ne parla molto spesso a sproposito
Gli odontoiatri sono stati i primi a cercare un’alternativa per far crescere l’osso dei denti dove mancava osso/smalto. In campo ortopedico invece è una terapia utile soprattutto per la cartilagine.
Infatti sono molto utili per curare le lesioni muscolari.
Chi subisce una lesione muscolare può accelerare la riparazione della lesione muscolare con delle infiltrazioni con i fattori di crescita.
In cosa consistono le infiltrazioni con i Fattori di Crescita?
Si preleva del sangue dal braccio, da una vena periferica, come in un comune prelievo del sangue e questo sangue viene centrifugato ad una particolare velocità provocando la separazione delle componenti, le piastrine, che poi, con un reagente, vengono interrotte.
Da questa centrifuga di piastrine escono fuori tante piccole proteine che si chiamano fattori di crescita che hanno un potere riparativo e rigenerativo nei confronti sia della cartilagine, delle fibre muscolari e dei tendini veramente molto importante.
Quando è consigliabile farlo e qual’è, se c’è, una situazione in cui è meglio non abusare di queste piccole proteine, di questi fattori di crescita?
In un certo senso i fattori di crescita sono un prodotto “nostro” e quindi non parliamo di un farmaco, non è un intervento chirurgico per cui possiamo tranquillamente utilizzarlo anche a dismisura come dispositivo.
Certamente magari può non funzionare però non fa assolutamente male, è proprio del sangue nostro e quindi non rischieremmo neppure delle crisi allergiche come ad esempio possono accadere nei casi di sostanze esterne.
IN quali casi vengono utilizzati i Fattori di Crescita?
L’impiego avviene in tanti casi: sia in casi acuti, come ad esempio nelle lesioni muscolari entro i primi 7/10 giorni dal trauma ma anche in fasi croniche per esempio vengono trattate tante spalle, cuffie dei rotatori che hanno delle tendiniti croniche quindi hanno una lesione proprio del tendine specialmente negli sportivi.